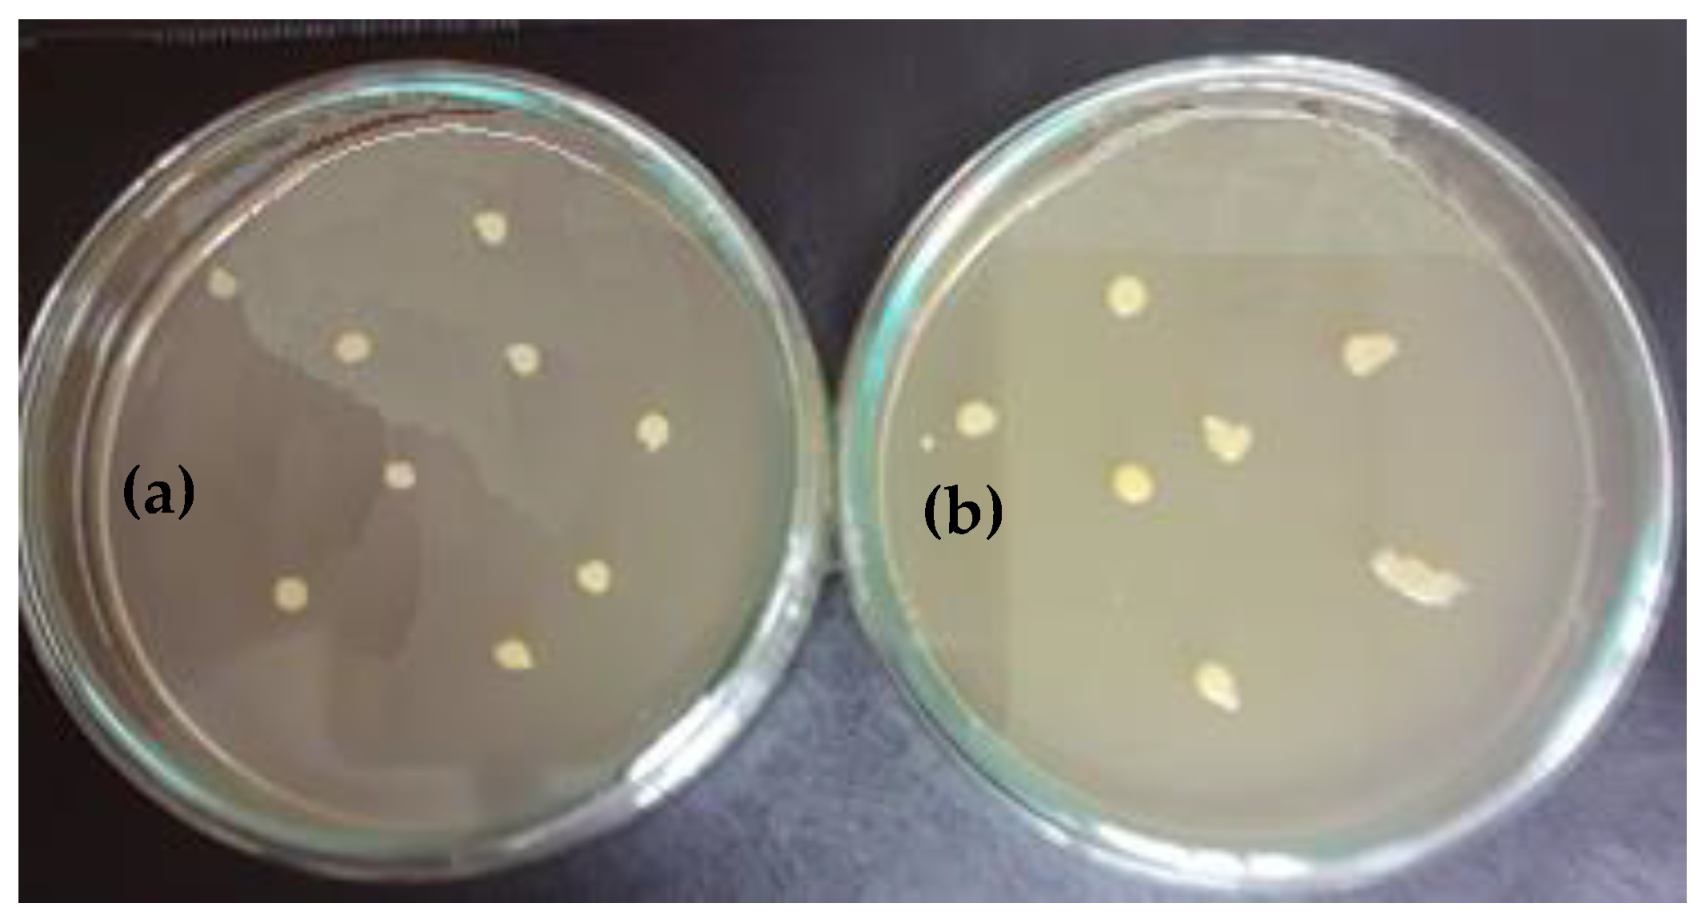
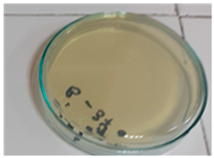

Nanocomposite Biopolymer Arboblend V2 Nature AgNPs
Abstract
:1. Introduction
2. Materials and Methods
2.1. Thermal Analysis
2.2. Structural and Morphological Analyses
2.3. Antibacterial Analysis
2.3.1. Biological Material
- A total 5 test tubes were prepared with 9ml of liquid culture medium for each bacterial tuple to be tested;
- Cell suspension of 1 mL was taken from the obtained inoculum, and was introduced into the first test tube with the liquid culture medium. It was homogenized very well and then serial dilutions are made until 10−5 dilution;
- In total, 5 sterile Petri plates were prepared, in which approximately (20–25) mL of agarized culture medium was poured. After solidification, the surface of the medium was inoculated with 0.1 mL of cell dilution suspension from 10−5 to 10−1. The suspension was uniformized on the surface of the culture medium by means of a sterile bacteriological loop, and then it was incubated for 24–48 h (as appropriate) for cell development and colony formation.
2.3.2. Submerged Culture of Bacterial Strains in the Presence of the Test Sample
3. Results
3.1. The DSC Analysis
3.2. The TGA Analysis
3.3. Surface and Structure Analysis for P1 and P2 Samples
3.3.1. SEM Analysis
3.3.2. EDX Analysis
3.3.3. XRD Analysis
- There is a crystallization at an angle of 16.24° with an intensity of 17,163.61, which, according to the literature, can be associated with the presence of the composition of polylactic acid (C3H4O2, PLA) [35,36,37]. The presence of which is not surprising, since the manufacturers indicate it as a possible constituent of this biopolymer;
- The second major peak appears at an angle of 13.43° with an intensity of 4685.61, which corresponds to the lactone crystallization [38];
3.4. Highlighting the Biocidal Activity of an Arboblend V2 Nature Sample Obtained by Injection into the Mold of Granules Coated with Silver Nanoparticles
- In the sample coated with silver nanoparticles, an inhibition of the bacterium growth was observed, and the number of colonies that could be counted was at the 105 (7 × 105 UFC/mL) dilution. At 106 to 108 dilutions, no colony developed on the surface of the culture medium. However, a slight numerical increase was found compared to the amount of cells introduced in the experiment, which is probably due to the initial phase of development up until the diffusion of silver nanoparticles in the culture medium.
4. Conclusions
- From the DSC analysis point of view, the incorporation of nanoparticles led to a slight decrease in the transition temperatures;
- The thermogravimetric analysis indicated a slight reduction in the thermal stability of the injected samples against the granules;
- The peaks identified during the XRD analysis clearly demonstrate the existence of crystalline phases in the biodegradable thermoplastic material, examined both in its pure version and in the one containing silver nanoparticles. The identification of the peaks was only observed for those of significant intensity. Based on these, as well as thermal analysis and data from the literature, the appropriate hypothesis that the Arboblend V2 Nature and AgNPs sample has a semicrystalline structure was confirmed. Furthermore, the presence of silver nanoparticles in the biopolymer composition was confirmed by structural and morphological investigations: EDX, XRD and SEM.
Author Contributions
Funding
Data Availability Statement
Conflicts of Interest
References
- Motas, J.G.; Quadrini, F.; Nedelcu, D. Silver Nano-Coating of Liquid Wood for Nanocomposite Manufacturing. Procedia Manuf. 2020, 47, 974–979. [Google Scholar] [CrossRef]
- Burrell, R.E. A scientific perspective on the use of topical silver preparations. Ostomy Wound Manag. 2003, 49, 19–24. [Google Scholar]
- Feng, Q.L.; Wu, J.; Chen, G.Q.; Cui, F.Z.; Kim, T.N.; Kim, J.O.J. A mechanistic study of the antibacterial effect of silver ions on Escherichia coli and Staphylococcus aureus. Biomed. Mater. Res. 2000, 52, 662–668. [Google Scholar] [CrossRef]
- Berger, T.J.; Spadaro, J.A.; Chapin, S.E.; Becker, R.O. Electrically generated silver ions: Quantitative effects on bacterial and mammalian cells. Antimicrob. Agents Chemother 1976, 9, 357–358. [Google Scholar] [CrossRef] [PubMed] [Green Version]
- Russell, A.D.; Hugo, W.B. 7 antimicrobial activity and action of silver. Prog. Med. Chem. 1994, 31, 351–370. [Google Scholar]
- Fages, E.; Pascual, J.; Fenollar, O.; García-Sanoguera, D.; Balart, R. Study of antibacterial properties of polypropylene filled with surfactant-coated silver nanoparticles. Polym. Eng. Sci. 2011, 51, 804–811. [Google Scholar] [CrossRef]
- Wright, J.B.; Lam, K.; Hansen, D.; Burrell, R.E. Efficacy of topical silver against fungal burn wound pathogens. Am. J. Infect. Control 1999, 27, 344–350. [Google Scholar] [CrossRef]
- Knetsch, M.L.W.; Koole, L.H. New Strategies in the Development of Antimicrobial Coatings: The Example of Increasing Usage of Silver and Silver Nanoparticles. Polymers 2011, 3, 340–366. [Google Scholar] [CrossRef]
- Quadrini, F.; Bellisario, D.; Santo, L.; Tedde, G.M. Anti-Bacterial Nanocomposites by Silver Nano-Coating Fragmentation. Mater. Sci. Forum 2016, 879, 1540–1545. [Google Scholar] [CrossRef]
- Bellisario, D.; Quadrini, F.; Santo, L.; Tedde, G.M. Manufacturing of Antibacterial Additives by Nano-Coating Fragmentation. In Proceedings of the ASME 2018 13th International Manufacturing Science and Engineering Conference. Volume 2: Materials; Joint MSEC-NAMRC-Manufacturing USA. V002T04A011, ASME, College Station, TX, USA, 18–22 June 2018. [Google Scholar] [CrossRef]
- Palza, H. Antimicrobial Polymers with Metal Nanoparticles. Int. J. Mol. Sci. 2015, 16, 2099–2116. [Google Scholar] [CrossRef] [Green Version]
- Bankura, K.; Maity, D.; Mollick, M.M.; Mondal, D.; Bhowmick, B.; Bain, M.; Chakraborty, A.; Sarkar, J.; Acharya, K.; Chattopadhyay, D. Synthesis, characterization and antimicrobial activity of dextran stabilized silver nanoparticles in aqueous medium. Carbohydr. Polym. 2012, 89, 1159–1165. [Google Scholar] [CrossRef]
- Kanmani, P.; Lim, S.T. Synthesis and characterization of pullulan-mediated silver nanoparticles and its antimicrobial activities. Carbohydr. Polym. 2013, 97, 421–428. [Google Scholar] [CrossRef]
- Liu, Y.; Chen, S.; Zhong, L.; Wu, G. Preparation of high-stable silver nanoparticle dispersion by using sodium alginate as a stabilizer under gamma radiation. Radiat. Phys. Chem. 2009, 78, 251–255. [Google Scholar] [CrossRef]
- Bahrami, A.; Mokarram, R.R.; Khiabani, M.S.; Ghanbarzadeh, B.; Salehi, R. Physico-mechanical and antimicrobial properties of tragacanth/hydroxypropyl methylcellulose/beeswax edible films reinforced with silver nanoparticles. Int. J. Biol. Macromol. 2019, 129, 1103–1112. [Google Scholar] [CrossRef]
- Incoronato, A.I.; Buonocore, G.G.; Conte, A.; Lavorgna, M.; Del Nobile, M.A. Active Systems Based on Silver-Montmorillonite Nanoparticles Embedded into Bio-Based Polymer Matrices for Packaging Applications. J. Food Prot. 2010, 73, 2256–2262. [Google Scholar] [CrossRef] [PubMed]
- Orsuwan, A.; Shankar, S.; Wang, L.-F.; Sothornvit, R.; Rhim, J.-W. One-step preparation of banana powder/silver nanoparticles composite films. J. Food Sci. Technol. 2017, 54, 497–506. [Google Scholar] [CrossRef] [PubMed] [Green Version]
- Rhim, J.W.; Wang, L.F.; Hong, S.I. Preparation and characterization of agar/silver nanoparticles composite films with antimicrobial activity. Food Hydrocoll. 2013, 33, 327–335. [Google Scholar] [CrossRef]
- Youssef, A.M.; Abdel-Aziz, M.S.; El-Sayed, S.M. Chitosan nanocomposite films based on Ag-NP and Au-NP biosynthesis by Bacillus subtilis as packaging materials. Int. J. Biol. Macromol. 2014, 69, 185–191. [Google Scholar] [CrossRef]
- Cushen, M.; Kerry, J.; Morris, M.; Cruz-Romero, M.; Cummins, E. Migration and exposure assessment of silver from a PVC nanocomposite. Food Chem. 2013, 139, 389–397. [Google Scholar] [CrossRef] [PubMed]
- Lansdown Alan, B.G. Silver in Health Care: Antimicrobial Effects and Safety in Use. In Biofunctional Textiles and the Skin; Karger Publishers: Basel, Switzerland, 2006; pp. 7–34. [Google Scholar]
- Li, L.; Bi, Z.; Hu, Y.; Sun, L.; Song, Y.; Chen, S.; Mo, F.; Yang, J.; Wei, Y.; Wei, X. Silver nanoparticles and silver ions cause inflammatory response through induction of cell necrosis and the release of mitochondria in vivo and in vitro. Cell Biol. Toxicol. 2021, 37, 177–191. [Google Scholar] [CrossRef] [PubMed]
- De Matteis, V.; Cascione, M.; Toma, C.C.; Leporatti, S. Morphomechanical and organelle perturbation induced by silver nanoparticle exposure. J. Nanopart. Res. 2018, 20, 273. [Google Scholar] [CrossRef]
- Xiao, X.; He, E.J.; Lu, X.R.; Wu, L.J.; Fan, Y.Y.; Yu, H.Q. Evaluation of antibacterial activities of silver nanoparticles on culturability and cell viability of Escherichia coli. Sci. Total Environ. 2021, 794, 148765. [Google Scholar] [CrossRef]
- Stabryla, L.M.; Johnston, K.A.; Diemler, N.A.; Cooper, V.S.; Millstone, J.E.; Haig, S.-J.; Gilbertson, L.M. Role of bacterial motility in differential resistance mechanisms of silver nanoparticles and silver ions. Nat. Nanotechnol. 2021. [Google Scholar] [CrossRef]
- TECNARO-The Biopolymer Company. Available online: https://www.tecnaro.de/en/ (accessed on 12 August 2020).
- Suh, I.-K.; Ohta, H.; Waseda, Y. High-temperature thermal expansion of six metallic elements measured by dilatation method and X-ray diffraction. J. Mater. Sci. 1988, 23, 757–760. [Google Scholar] [CrossRef]
- Mazurchevici, S.-N.; Mazurchevici, A.-D.; Nedelcu, D. Dynamical Mechanical and Thermal Analyses of Biodegradable Raw Materials for Additive Manufacturing. Materials 2020, 13, 1819. [Google Scholar] [CrossRef] [PubMed] [Green Version]
- Wagner, M. Thermal Analysis in Practice, Fundamental Aspects. In Thermal Analysis in Practice; Wagner, M., Ed.; Hanser: München, Germany, 2018; pp. 1–9. ISBN 9781569906439. [Google Scholar]
- Brebu, M.; Vasile, C. Thermal degradation of lignin—A review. Cell Chem. Technol. 2010, 44, 353–363. [Google Scholar]
- Cai, Y.H.; Xie, Y.C.; Tang, Y.; Zhao, L.S. Thermal Decomposition Kinetics of Poly(L-lactic acid) after Heat Treatment. Open Mater. Sci. J. 2015, 9, 28–32. [Google Scholar] [CrossRef] [Green Version]
- Prieur, B.; Meub, M.; Wittemann, M.; Klein, R.; Bellayer, S.; Fontaine, G.; Bourbigot, S. Phosphorylation of lignin: Characterization and investigation of the thermal decomposition. RSC Adv. 2017, 7, 16866–16877. [Google Scholar] [CrossRef] [Green Version]
- Chien, Y.C.; Liang, C.; Liu, S.H.; Yang, S.H. Combustion Kinetics and Emission Characteristics of Polycyclic Aromatic Hydrocarbons from Polylactic Acid Combustion. J. Air Waste Manag. Assoc. 2012, 60, 849–855. [Google Scholar] [CrossRef] [PubMed] [Green Version]
- Sameni, J.; Krigstin, S.; Rosa, D.d.S.; Leao, A.; Sain, M. Thermal Characteristics of Lignin Residue from Industrial Processes. BioResources 2014, 9, 725–737. [Google Scholar] [CrossRef] [Green Version]
- Benwood, C.; Anstey, A.; Andrzejewski, J.; Misra, M.; Mohanty, A.K. Improving the Impact Strength and Heat Resistance of 3D Printed Models: Structure, Property, and Processing Correlationships during Fused Deposition Modeling (FDM) of Poly(Lactic Acid). ACS Omega 2018, 3, 4400–4411. [Google Scholar] [CrossRef] [PubMed]
- Plastics Technology. Available online: https://www.ptonline.com/knowledgecenter/plastics-feeding/application-profiles (accessed on 9 August 2020).
- De Teixeira, E.M.; de Campos, A.; Marconcini, J.M.; Bondancia, T.J.; Wood, D.; Klamczynski, A.; Mattosoa, L.H.C.; Glenn, G.M. Starch/fiber/poly(lactic acid) foam and compressed foam composites. RSC Adv. 2014, 4, 6616–6623. [Google Scholar] [CrossRef]
- Hancock, B.C.; Zografi, G. Characteristics and significance of the amorphous state in pharmaceutical systems. J. Pharm. Sci. 1997, 86, 1–12. [Google Scholar] [CrossRef]
- Cai, X.; Lei, T.; Sund, D.; Linde, L. A critical analysis of the a, b and g phases in poly(vinylidene fluoride) using FTIR. RSC Adv. 2017, 7, 15382. [Google Scholar] [CrossRef] [Green Version]
- Janakiraman, S.; Abhijith, S.; Sudipto, G.; Anandhan, S.; Venimadhav, A. Electroactive poly(vinylidene fluoride) fluoride separator for sodium ion battery with high coulombic efficiency. Solid State Ion. 2016, 292, 130–135. [Google Scholar] [CrossRef]
- Poletto, M.; Ornaghi, H.L.; Zattera, A.J. Native Cellulose: Structure, Characterization and Thermal Properties. Materials 2014, 7, 6105–6119. [Google Scholar] [CrossRef] [Green Version]
- Kaushik, V.K.; Kumar, A.; Kalia, S. Effect of Mercerization and Benzoyl Peroxide Treatment on Morphology, Thermal Stability and Crystallinity of Sisal Fibers. Int. J. Text. Sci. 2012, 1, 101–105. [Google Scholar] [CrossRef]
- Kuo, Y.L.; Chen, H.W.; Ku, Y. Analysis of silver particles incorporated on TiO2 coatings for the photodecomposition of o-cresol. Thin Solid Films 2007, 515, 3461–3468. [Google Scholar] [CrossRef]
- Loo, Y.Y.; Chieng, B.W.; Nishibuchi, M.; Radu, S. Synthesis of silver nanoparticles by using tea leaf extract from Camellia Sinensis. Int. J. Nanomed. 2012, 7, 4263–4267. [Google Scholar] [CrossRef] [Green Version]
- Koohpeima, F.; Mokhtari, M.J.; Khalafi, S. The effect of silver nanoparticles on composite shear bond strength to dentin with different adhesion protocols. J. Appl. Oral Sci. 2017, 25, 367–373. [Google Scholar] [CrossRef]
- Palomba, M.; Carotenuto, G.; Cristino, L.; Di Grazia, M.A.; Nicolais, F.; De Nicola, S. Activity of Antimicrobial Silver Polystyrene Nanocomposites. J. Nanomater. 2012, 185029. [Google Scholar] [CrossRef] [Green Version]
- Damm, C.; Münstedt, H. Kinetic aspects of the silver ion release from antimicrobial polyamide/silver nanocomposites. Appl. Phys. A 2008, 91, 479–486. [Google Scholar] [CrossRef]
- Jokar, M.; Abdul Rahman, R.; Ibrahim, N.A.; Abdullah, L.C.; Tan, C.P. Melt production and antimicrobial efficiency of low-density polyethylene (LDPE)-silver nanocomposite film. Food Bioprocess. Technol. 2010, 5, 719–782. [Google Scholar] [CrossRef]
- Tang, J.; Chen, Q.; Xu, L.; Zhang, S.; Feng, L.; Cheng, L.; Xu, H.; Liu, Z.; Peng, R. Graphene oxide-silver nanocomposite as a highly effective antibacterial agent with species-specific mechanisms. ACS Appl. Mater. Interfaces 2013, 5, 3867–3874. [Google Scholar] [CrossRef]
- Ahari, H.; Karim, G.; Anvar, A.A.; Pooyamanesh, M.; Sajadi, A.; Mostaghim, A.; Heydari, S. Synthesis of the Silver Nanoparticle by Chemical Reduction Method and Preparation of Nanocomposite based on AgNPS. In Proceedings of the 4th World Congress on Mechanical, Chemical, and Material Engineering, MCM’18, Paper No. ICCPE 125, Madrid, Spain, 16–18 August 2018. [Google Scholar] [CrossRef]

| Ingredients | g/L | ![]() |
| Tryptose | 15.0 | |
| Soy pepper | 5.0 | |
| Dextrose | 5.5 | |
| L-cysteine | 0.7 | |
| Sodium chloride | 4.0 | |
| Sodium sulfite | 0.2 | |
| Agar | 15.0 |
| Transformation | Tonset [°C] | Tpeak [°C] | Tend [°C] | ΔH/m [kJ/kg] | |
|---|---|---|---|---|---|
| P1 | I | 66.4 | 70.2 | 74.6 | −12.68 |
| II | 86.9 | 93.6 | 100.5 | 22.35 | |
| III | 162.3 | 174.2 | 179.6 | −37.1 | |
| P2 | I | 61.3 | 65.2 | 69.8 | −5.66 |
| II | 81.6 | 87.2 | 94.4 | 23.57 | |
| III | 167.1 | 172.6 | 178.6 | −38.85 |
| Sample | Stage | Tonset [°C] | Tpeak [°C] | Tend [°C] | W [%] | DTA characteristic | Residue [%] |
|---|---|---|---|---|---|---|---|
| P1 | I | 295 | 348 | 371 | 83.80 | exo | 5.09 |
| II | 410 | 422 | 433 | 11.11 | exo | ||
| P2 | I | 291 | 346 | 371 | 84.44 | exo | 3.82 |
| II | 413 | 424 | 442 | 11.74 | exo |
Publisher’s Note: MDPI stays neutral with regard to jurisdictional claims in published maps and institutional affiliations. |
© 2021 by the authors. Licensee MDPI, Basel, Switzerland. This article is an open access article distributed under the terms and conditions of the Creative Commons Attribution (CC BY) license (https://creativecommons.org/licenses/by/4.0/).
Share and Cite
Mazurchevici, S.-N.; Motaș, J.G.; Diaconu, M.; Lisa, G.; Lohan, N.M.; Glod, M.; Nedelcu, D. Nanocomposite Biopolymer Arboblend V2 Nature AgNPs. Polymers 2021, 13, 2932. https://doi.org/10.3390/polym13172932
Mazurchevici S-N, Motaș JG, Diaconu M, Lisa G, Lohan NM, Glod M, Nedelcu D. Nanocomposite Biopolymer Arboblend V2 Nature AgNPs. Polymers. 2021; 13(17):2932. https://doi.org/10.3390/polym13172932
Chicago/Turabian StyleMazurchevici, Simona-Nicoleta, Justina Georgiana Motaș, Mariana Diaconu, Gabriela Lisa, Nicoleta Monica Lohan, Mihai Glod, and Dumitru Nedelcu. 2021. "Nanocomposite Biopolymer Arboblend V2 Nature AgNPs" Polymers 13, no. 17: 2932. https://doi.org/10.3390/polym13172932
APA StyleMazurchevici, S.-N., Motaș, J. G., Diaconu, M., Lisa, G., Lohan, N. M., Glod, M., & Nedelcu, D. (2021). Nanocomposite Biopolymer Arboblend V2 Nature AgNPs. Polymers, 13(17), 2932. https://doi.org/10.3390/polym13172932